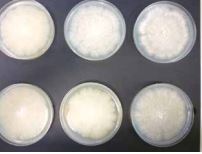
Odjel za biologiju – predstavljanje četiri institucijska projekta

Odjel za biologiju – predstavljanje četiri institucijska projekta
SVEUČILIŠNI GLASNIK BR. 78.
5-78Preuzmi
5. sjednica Senata Sveučilišta Josipa Jurja Strossmayera u Osijeku održana 9....
SVEUČILIŠNI GLASNIK BR. 78.
2-78Preuzmi
Međužupanijski stručni skup – Znanstvena postignuća u biologiji
SVEUČILIŠNI GLASNIK BR. 77.
16-77Preuzmi
Potpisan sporazum o znanstveno-stručnoj suradnji između Prehrambeno-tehnološkog fakulteta Osijek, Odjela za...
SVEUČIIŠNI GLASNIK BR. 77.
13-77Preuzmi
Jedinstvena sveučilišna studentska anketa u akademskoj 2020./2021. godini
SVEUČILIŠNI GLASNIK BR. 76.
8-76Preuzmi
Odjel za biologiju Sveučilišta Josipa Jurja Strossmayera u Osijeku – institucijski...
SVEUČILIŠNI GLASNIK BROJ 76.
5-76Preuzmi